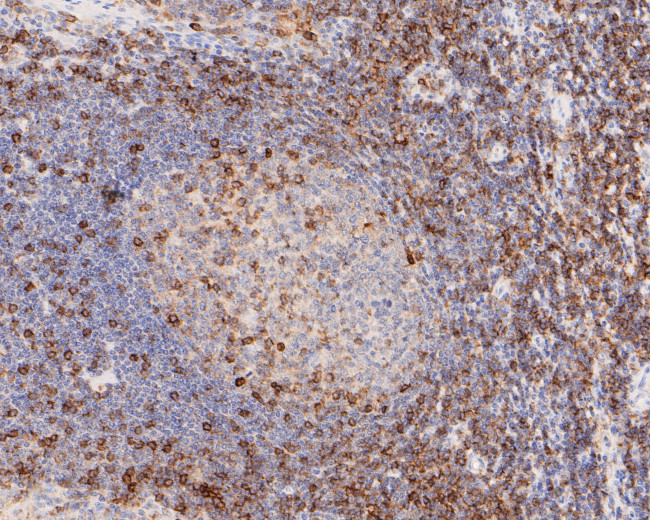
CD43 Antibody in Immunohistochemistry (Paraffin) (IHC (P))

Search
Huabio
CD43 Monoclonal Antibody (A2F7)
{{$productOrderCtrl.translations['antibody.pdp.commerceCard.promotion.promotions']}}
{{$productOrderCtrl.translations['antibody.pdp.commerceCard.promotion.viewpromo']}}
{{$productOrderCtrl.translations['antibody.pdp.commerceCard.promotion.promocode']}}: {{promo.promoCode}} {{promo.promoTitle}} {{promo.promoDescription}}. {{$productOrderCtrl.translations['antibody.pdp.commerceCard.promotion.learnmore']}}
图: 1 / 4
CD43 Antibody (EM1901-92) in IHC (P)




产品信息
EM1901-92
种属反应
宿主/亚型
分类
类型
克隆号
抗原
偶联物
形式
浓度
规格
纯化类型
保存液
内含物
保存条件
运输条件
靶标信息
CD43, also known as leukosialin or sialophorin, is a transmembrane mucin-like protein characterized by a high negative charge. It is expressed on the surface of most hematopoietic cells, excluding resting B lymphocytes. CD43 serves both adhesive and anti-adhesive functions, contributing to a repulsive barrier that can interfere with cellular adhesion while also promoting leukocyte aggregation in certain contexts. CD43 is involved in the activation of T cells, B cells, NK cells, and monocytes. Its expression decreases upon activation due to proteolytic processing. The counter-receptor for CD43 is CD169/SIGLEC-1, which is expressed on macrophages. CD43 interacts with actin-binding proteins ezrin and moesin, playing a regulatory role in remodeling T-cell morphology and regulating cell-cell interactions during lymphocyte traffic. It enhances LFA-1 adhesiveness while counteracting LFA-1 induction via other receptors. CD43 signaling induces the functionally active tumor suppressor p53 protein, but in cases of p53 and ARF deficiency, it can promote tumor proliferation and viability. CD43 is an important modulator of leukocyte functions, with dysfunctions associated with diseases such as Wiscott-Aldrich Syndrome and Adenoid Basal Cell Carcinoma.
仅用于科研。不用于诊断过程。未经明确授权不得转售。
篇参考文献 (0)
生物信息学
蛋白别名: CD43; Galactoglycoprotein; GALGP; GPL115; Leukocyte sialoglycoprotein; Leukosialin; Sialophorin; sialophorin (gpL115, leukosialin, CD43); sialophorin gpL115; sialophorin precursor; unnamed protein product
基因别名: CD43; GALGP; GPL115; LEU-22; LSN; SPN
UniProt ID: (Human) P16150
Entrez Gene ID: (Human) 6693